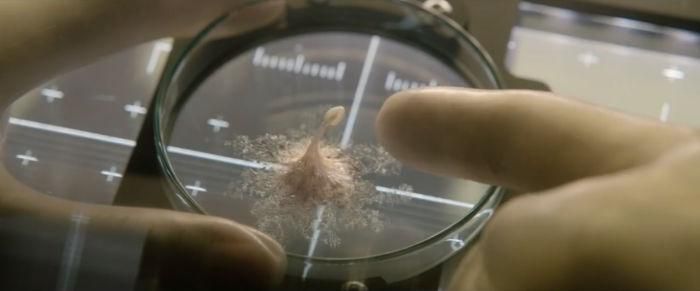

映画「ライフ」みてきました。イオン天童店です。火星で生命体を発見して宇宙ステーションで実験するストーリーでした。平日のためか観客は私一人でした。貸し切り状態で、とっても贅沢な気分でした。周りを気にしなくていいので、ハラハラドキドキの場面では、思いっきり体をよじらせて、さすがに声は出しませんでしたが、みてきました。それで★★★★でした。なかなかおもしろかったです。
帰ってきたヒトラー DVDみた
「帰ってきたヒトラー」DVDみました。おもしろかった。
★★★☆かな?前からみたかったのですが、映画館では(費用的に)チョット。と思っていたんですが、ツタヤで見かけたんで借りてみました。結構おもしろかった。今の時代、あんな人が出てきたらほんとやばいですね。ヨーロッパではそんな情勢にもなってるし。
TAP THE LAST SHOW 水谷豊監督作品みてきました。

TAP THE LAST SHOW 水谷豊が初めての監督作品みてきました。NHKの朝のニュース特集でインタビュー受けているのをみて、よし!これだ!と思いました。水谷自身が20代の頃から、こういうのを撮ってみたい。と、温めていた作品だそうです。又、水谷自身が悩んだのが、プロの俳優にタップを習わせるのか、プロのタップダンサーに俳優させるのか、だったそうです。で、決断したのが、プロのタップダンサーのタップがすごすぎて、プロのタップダンサーの方にしたそうです。こりゃー観るしかないっしょ!てな感じで、どこで上映しているか検索したら山形のMOVIE ONで上映してた。なるほどタップダンスすごい。これだけでも感動です。水谷豊いやぁ~!よかった。渋かった。タップダンス迫力ありました。MAKOTOの恋人役「北乃きい」かわいいねぇ。事務員役の「さな」ダンサーの「太田彩乃」「佐藤瑞季」みんなよかった!最後泣けました。よって★★★★☆です。観てきてよかった。 追伸「佐藤瑞季」ネットみるとすごい可愛かったんだけど、太りすぎじゃネ!役作り? まっ、これはこれで可愛かったんですけど!
ブラムBLAME!みてきました。
ブラムBLAME!みてきました。SFアニメの劇場版です。ちょっと迷ったんですが、みてよかったと思います。この年で最後までみることができるかなぁ?なんて思っていました。結果★★★☆てなとこかな!最後まで飽きませんでした。物語的には全然終わっていないので、次回ありそうな終わり方でした。最近、次回ありそうな終わり方が多くて、スッキリこれで終了という映画がなくなってきましたねぇ。
「ワイルド・スピード ICE BREAK」みてきました。

「ワイルド・スピード ICE BREAK」みてきました。おもしろかったです。これは、なにも考えず見るのが一番です。考えちゃうときりがありません。核爆弾とか、潜水艦とか、回を追うごとに話が大きくなって、世界的規模のしかも核爆弾などの話になっちゃいました。なので、冒頭で言ったように、派手なアクションを楽しみました。★★★☆かな!